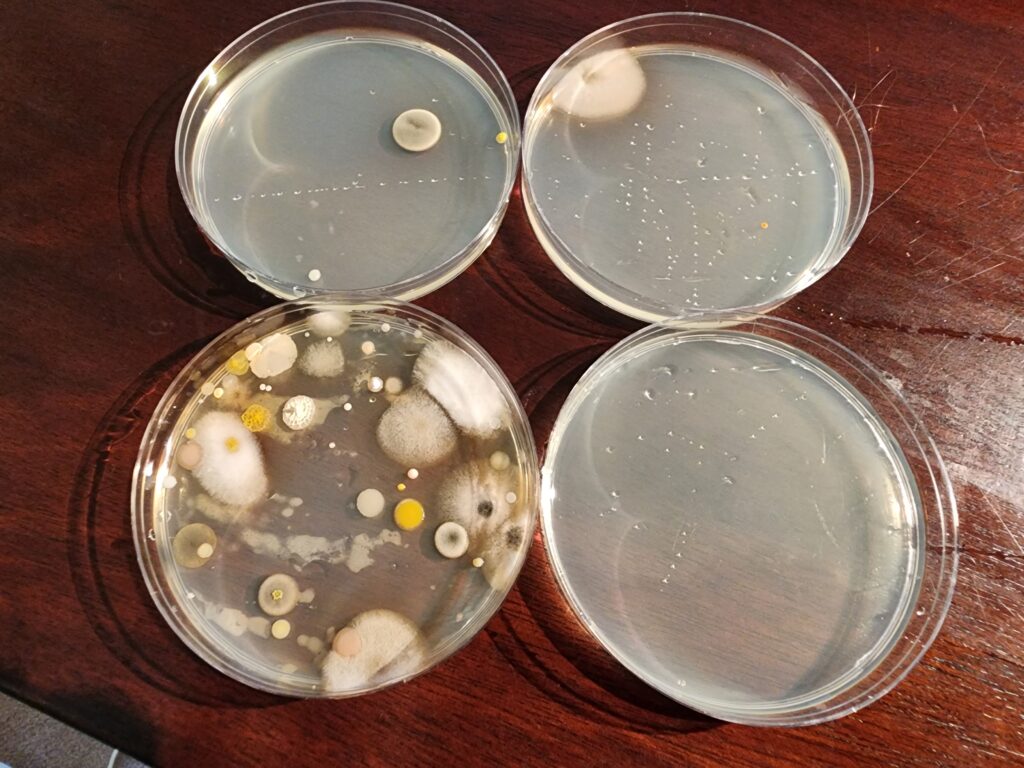

I spent yesterday evening working on getting a testing plan. I suspect it’s doable but the deeper in I go I’m finding issues that have to be considered.
1. because the petri dishes are sticky they give us information about the stream of microorganisms flowing out of the dryer the entire time they are being exposed. The dish is catching and holding on to organisms the whole time. The glove juice samples dry hands and we don’t yet know what’s happening with the organisms there. We need to.
2. The absolute power in the petri dishes is that even though we don’t know all the organisms, we are using the same media to capture room air and dryer air so it’s the DIFFERENCE that matters. Also, I grew the organisms to maturity on purpose. The scientists like to count them when they are tiny. Much less impressive in court.
3. doing a dryer glove test will lose some of that data because the hands go from wet to dry.
4.The question that matters in court is how many organisms are on the hands when they are pulled out of the dryer, so the glove juice test will tell us that exactly plus it will finally identify every organism. That’s what we need to know. The risk at this point is that the glove juice won’t reflect the same things we found in the petri dishes but I think that risk has to be taken. If the after-dry sample of glove juice is loaded with different organisms in higher quantities than before the dryer is used you will win every case you bring. I am proceeding to get you a price to do the testing. Again – if you can get Cmbio and Zymo to call me things will speed up. I’m continuing to reach out. Spoke with a guy in Sacramento last night. Learned a ton.
5. this message started off to be about air. I wanted to acknowledge the part of your proposed testing document where you address the air as a source of microorganisms. I completely agree it should be tested but I currently know of no test that returns an accurate, 100% result They are all fraught with problems and the dryer companies know how to defeat them in court. I will dig deeper once I have the hand tests sorted out but as of this moment I think you lose if you try to discuss room air other than as an aside to the jury.
6. The simplest, most unavoidable issue in all of this work – hyper visual for a judge or jury – is the fact there are 6 grams of water sprayed all over the walls, floor, and user at EVERY dry. No exceptions. That’s a product cycle defect that is so egregious all the defendants should be forced to liquidate their businesses and pay it all to the class in damages. 100% of it. Bleah.